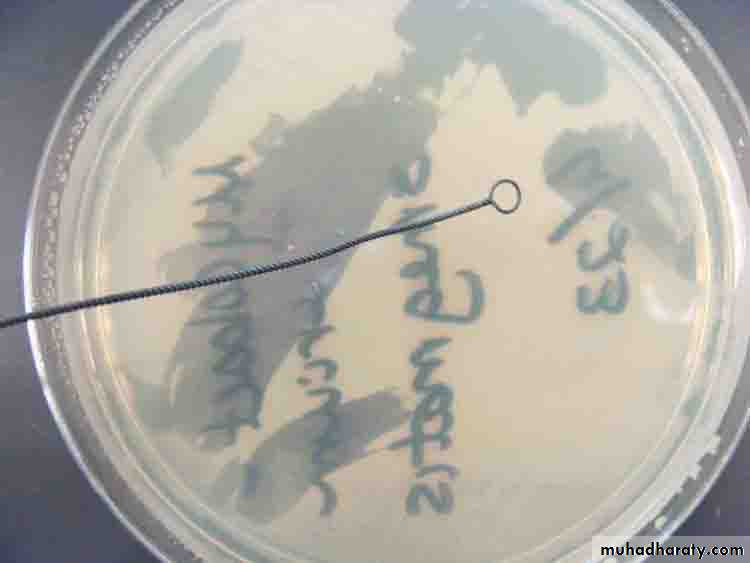

PRACTICAL MICROBIOLOGY
Dr. Waleed KhalidLAB:1
Laboratory Safety Rules,Microscope
and
Preparation of smear
Laboratory Safety Rules
There are specific safety rules that are needed to be followed while working in microbiology lab. These safety rules include :1-Wear a lab coat in the lab.
2-Eating, drinking and smoking are forbidden in microbiology lab.
3-Thoroughly wash your hands with soap and water before and after lab.
4-Clean the lab bench with disinfectant before and after lab.
5-Dispose of all contaminated materials and slides in specific containers.6-Bacterial loop has to be sterilized by flame before and after use.
LIGHT MICROSCOPE
- A basic microscope consists of two lenses. The uppermost lens, called the ocular lens which is the part through which a person looks. The lower lens is the objective lens. Usually, several objective lenses are localized on a turret, allowing rapid changing of objective lenses. The eyepiece tube holds the ocular and objective lenses in place. Most microbiological specimens are mounted on glass slides and placed on the stage.Procedure :
1 - Clean your lenses with lens paper.2 - Set the microscope on the scanning lens (red lens (4*)).
3 - Focus using the coarse adjustment.4 - Change to low power lens (yellow lens (10*)) and focus.
5 - Switch to high power lens (blue lens (40*)). Only use the fine adjustment knob.6 - Switch the objective to half way between the high power and the oil immersion lens (black and white) (100*) .
7 - Place a drop of oil on the slide.
8 - Turn oil immersion lens into the oil.
9 - Check your image and only use fine to adjust.
PREPARATION OF SMEAR :-
Preparation of fixed smear :-• A - From fluid material : ( such as broth culture , urine, sputum , pus , purulent exudates …, etc)
1 - Sterilize the loop in benzene flame , and let it to cool.
2 - Using a septic technique , withdraw a loopful of the specimen and spread it on the center of a clean slide to form a somewhat thick film of 1-2 cm in diameter , then re-sterilize the loop.
3 - Allow the film to dry by air without heating.
4 - The film is fixed on the slide by passing it 3 times through the benzene flame, allow the slide to cool before staining.B - From solid material: ( such as a culture on agar i.e colonies ) :
1 - Sterilize the loop in benzene flame and let it to cool.2 - Place a loopful of a clean water ( tap water can be used ) on the center of a clean slide.
3 - By the resterilized loop, transfer a small portion of the colony to the drop of water, emulsify thoroughly and spread the mixture evenly on the slide to form a thin film of 1-2 cm of diameter.